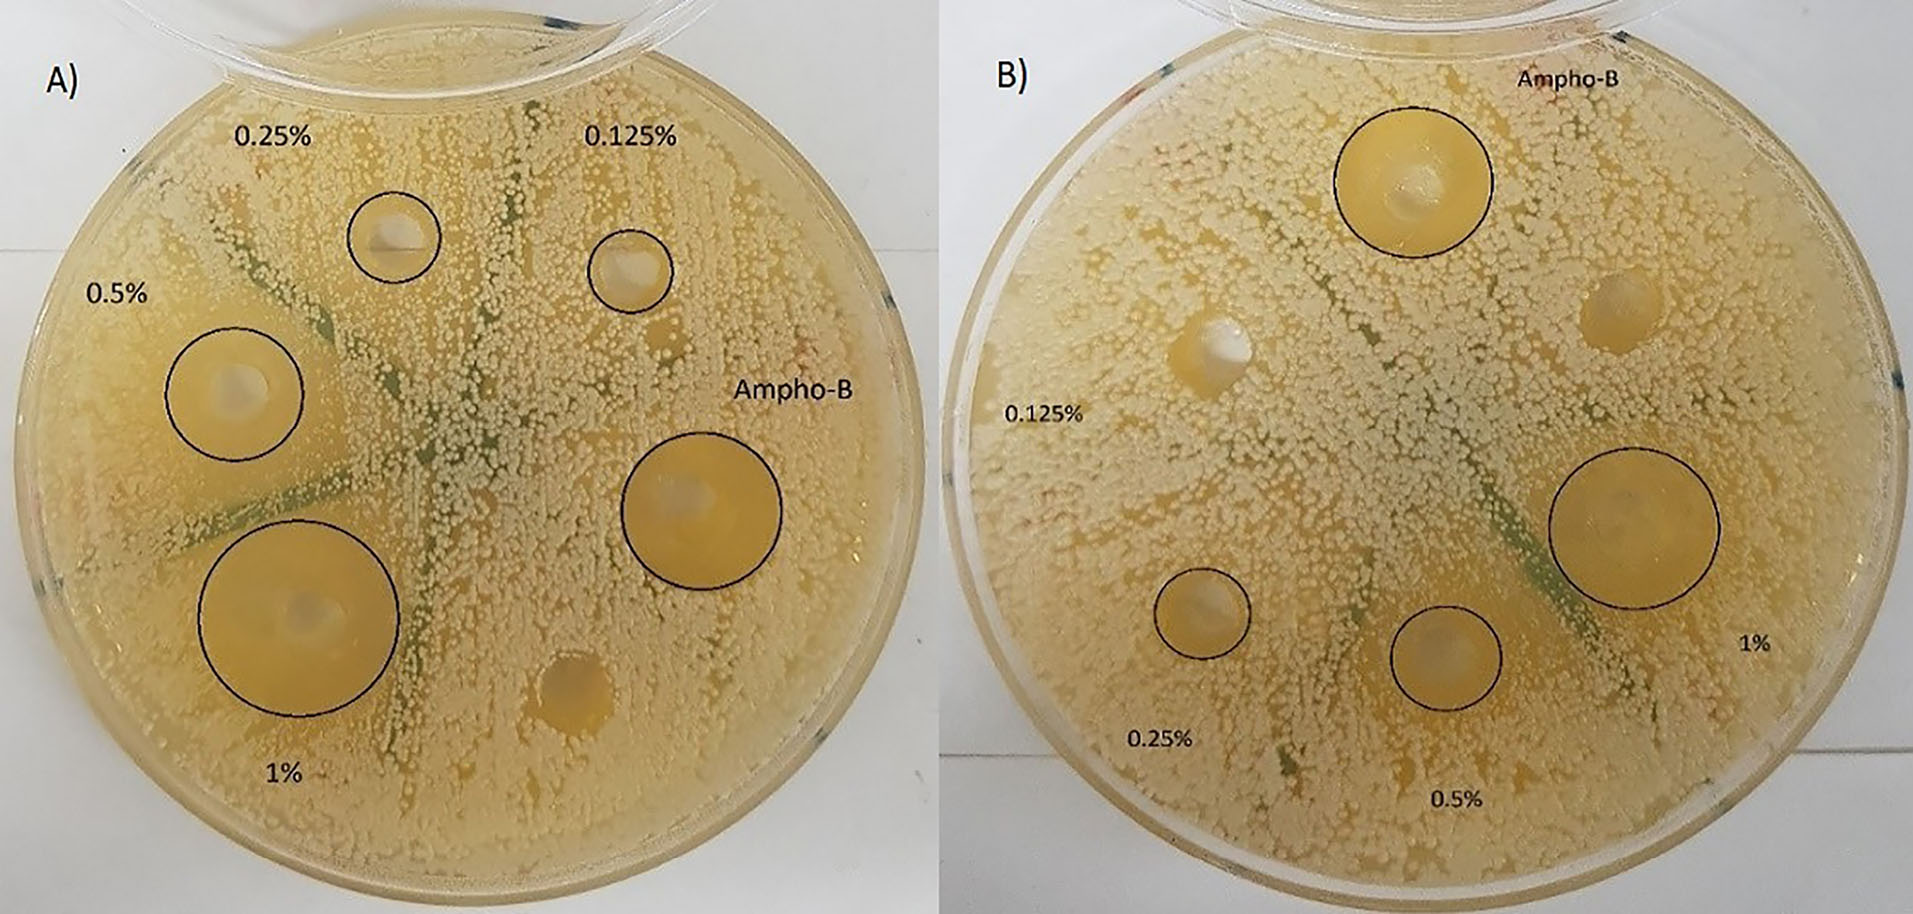
apb-11-327-g004
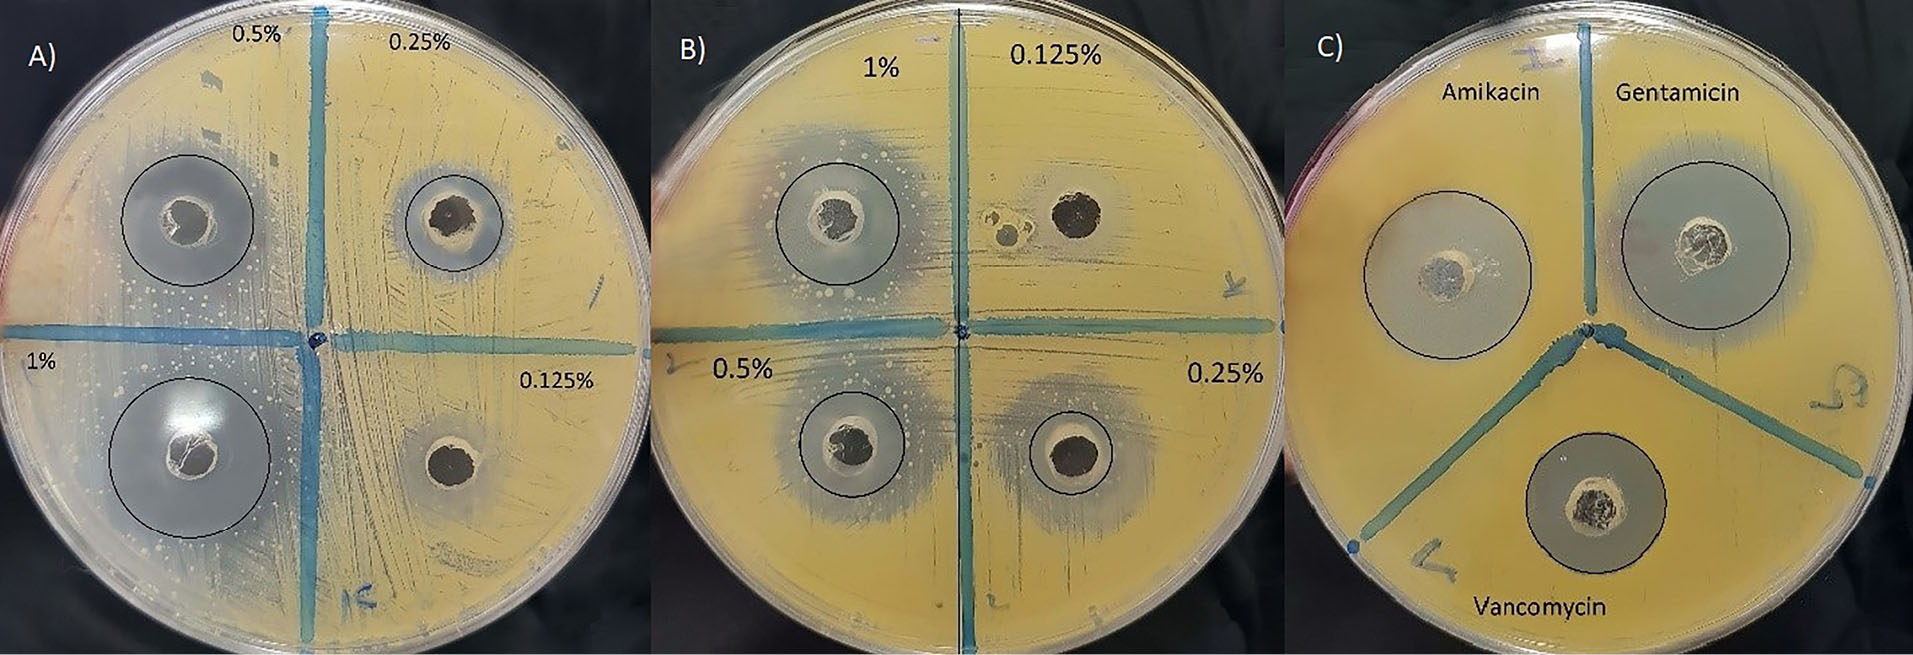
apb-11-327-g005

Advanced pharmaceutical bulletin. 11(2):327-334.
doi: 10.34172/apb.2021.028
Research Article
Anti-Microbial Potential of Nano-Emulsion form of Essential Oil Obtained from Aerial Parts of Origanum Vulgare L. as Food Additive
Reza Enayatifard 1  , Jafar Akbari 1, Amirhossein Babaei 2
, Jafar Akbari 1, Amirhossein Babaei 2  , Seyyed Sohrab Rostamkalaei 1, Seyyed Mohammad Hassan Hashemi 2, Emran Habibi 3, *
, Seyyed Sohrab Rostamkalaei 1, Seyyed Mohammad Hassan Hashemi 2, Emran Habibi 3, * 
Author information:
1Department of Pharmaceutics, Faculty of Pharmacy, Mazandaran University of Medical Sciences, Sari, Iran.
2Student Research Committee, Department of Pharmaceutics, Faculty of Pharmacy, Mazandaran University of Medical Sciences, Sari, Iran.
3Department of Pharmacognosy and Biotechnology, Pharmaceutical Sciences Research Center, Hemoglobinopathy Institute, Faculty of Pharmacy, Mazandaran University of Medical Sciences, Sari, Iran.
Abstract
Purpose:
Foodborne diseases are still a serious problem in public health and natural compounds are being widely considered for their potential industrial protective additive in food products. Origanum vulgare L. has been known as an antimicrobial effective herb. This present study was carried out to examine the antimicrobial effect of O. vulgare essential oil nanoemulsion in comparison with conventional emulsion.
Methods: The essential oil was obtained by hydrodistillation, analyzed by GC-Mass and formulated as a nanoemulsion to improve water dispersion by high-energy emulsification method. The antimicrobial activity of the prepared formulation was assessed by measuring the minimum inhibitory concentration (MIC), minimum bactericidal/fungicidal concentration (MBC/MFC) and zone of inhibition against some main foodborne pathogen microorganisms.
Results: The main component of the oregano essential oil was carvacrol (78%) and the selected nanoemulsion formulation demonstrated low polydispersity (0.11) and mean droplet (72.26 nm) and it was stable even after 30 days of storage. The nanoemulsion form displayed significant activity against the Staphylococcus aureus, Candida albicans and Aspergillus niger with inhibition zones ranging from 8.7–22.3 mm. The MIC of nanoemulsion against the tested bacteria was within the range of 0.156 to 0.312 (mg/mL) and against the tested fungi were in the range of 0.078 to 0.156 (mg/mL). The MBC/MFC of nanoemulsion against the tested microorganisms were in the range of 0.312 to 5 (mg/mL).
Conclusion: The study’s results demonstrated the possibility of using the nanoemulsion form of oregano essential oil as a food additive to inhibit the growth of some foodborne microorganisms and extending the shelf life of food products.
Keywords: Anti-microbial, Nanoemulsion, Essential oil, Origanum vulgare, Food additive
Copyright and License Information
© 2021 The Authors.
This is an Open Access article distributed under the terms of the Creative Commons Attribution (CC BY), which permits unrestricted use, distribution, and reproduction in any medium, as long as the original authors and source are cited. No permission is required from the authors or the publishers.
Introduction
Nowadays, microbial contamination of food is one of the major problems of the food industry and the general public health in the world. Foodborne disease for example diarrheal disease kills a lot of people in the world every year.1 Since long-term use of synthetic anti-microbial preservatives and food additives (like parabens) have adverse side effects and make changes to the natural form of foods, also the economic effects of corrupted foods and the consumer’s concerns over the safety of foods containing synthetic chemicals demonstrate the importance of using natural antimicrobial compounds or naturally derived compounds in food industries.2-4 If the level of synthetic antimicrobial compounds in foods is reduced, the need for other additives will be required to maintain the safety of food. One of the natural possibility is the use of essential oils obtained from plant materials as antimicrobial additives5-7 and in more recent studies examined for their effectiveness for food safety and preservation applications.8-10 Essential oils are complex blends of various different volatile and aromatic substances extracted from different plant organs that dissolve in low quantities in water and are used in the perfume and food industries as a fragrance and flavoring agent.11 Many essential oils have been displayed to possess strong antibacterial, antiviral, and antifungal effects.1,12,13
Origanum vulgare L., Lamiaceae family, also known as oregano is an annual, perennial and shrubby safe flavoring herb that traditionally used worldwide for its medicinal purposes (dental caries, indigestion, respiratory disorders, rheumatoid arthritis, and urinary tract disorders) at home remedy and distributed widely throughout Asia, particularly in Iran.14 Earlier studies have reported anti-mutagenic, anti-oxidant, anti-hyperglycemic, anti-fungal, anti-viral, anti-inflammatory and potent anti-bacterial effects of this plant.15 Also previous studies have shown that the O. vulgare essential oil has antioxidant capacity and anti-microbial effect which has been related to terpenoid and phenolic components such as thymol, carvacrol, γ-terpinene, p-cymene, sabinene, caryophyllene, germacrene, spathulenol.16,17 The low solubility of essential oils in water is a technological limitation in industry, so it needs new methods for formulation. Nanoemulsions as very small droplet-sized emulsions are new nanometric drug delivery systems that are used for bioactive components and because of their simplicity of formulation and acceptable functional properties like physicochemical, more stability and the potency of ameliorating biological activity of hydrophobic compounds (increasing the surface area and interactions between active ingredients with biological membranes), these are suitable for utilization in food products.2,18 New researches have demonstrated an improvement of the physical properties of essential oils-loaded nanoemulsions as to their similar typical emulsions and the use of nanosized delivery systems can potentially increase passive cell absorption mechanisms, thus reducing resistance to mass transfer and increasing antimicrobial action. Further, it has been also noted a higher antimicrobial activity in essential oils nanoemulsions.19-21 Prior to this, essential oil nanoemulsions were documented to be effective as antimicrobials; However, data on the advantages of using them against microorganisms in the food industry is currently limited. The purpose of the present study was outlined to produce stable nanoemulsion from O. vulgare and then examined its protective action against some selected food contaminant microorganisms.
Materials and Methods
Materials
Nonionic surfactant (Tween 80, Tween 20, Span 80), DMSO, Mueller-Hinton agar, Tryptic Soy broth, Tryptic Soy agar, Sabouraud Dextrose agar were purchased from Merck Millipore (Darmstadt, Germany). Staphylococcus aureus (PTCC 1112), Escherichia coli (PTCC 1330), Bacillus subtilis (PTCC 1023), Pseudomonas aeruginosa (PTCC 1074), Salmonella Typhi (PTCC 1609), Candida albicans (PTCC 5027), Aspergillus niger (PTCC 5011) were purchased from Persian Type Culture Collection (PTCC), Tehran, Iran.
Plant materials
The aerial parts of the cultivated Origanum vulgare L.subsp . vulgare (Lamiaceae) were collected in July 2016 from the Hezarjirib region of Mazandaran in Iran and dried at room temperature in the absence of sunlight. The collection was under specialist supervision and it was finally confirmed by senior plant taxonomist. The voucher specimens have been deposited at the Herbarium of the Department of Pharmacognosy (Voucher No: E1-36-491), Faculty of Pharmacy, Mazandaran University of Medical Sciences, Sari, Iran.
Essential oil isolation
The essential oil of aerial parts of O. vulgare was obtained using hydro-distillation for 4 hours by British type Clevenger apparatus. The obtained essential oil was dewatered with anhydrous sodium sulfate and stored under dark conditions at 4°C in a well-closed vial prior to use.
Gas chromatography/mass spectrometry analysis
Analyses by GC–MS were carried out by an Agilent 5975 GC-MSD system. HP 5MS equipped with a DB-1MS column (30×250 µm, 0.25 μm) were used with gas of helium as a mobile phase (40 mL/min). The temperature program was 50°C for 5 minutes, 5°C/min to 240°C, then 10°C/min to 290°C. The split ratio was 1:50 in this procedure. The injector temperature was modified to 290°C and mass spectra were recorded at 70 eV. The mass range was set up from 35 to 450 m/z. For the injection (split injector), 5 μL of essential oil was diluted in 500 μL of hexane, and 5 μL of this diluted solution was injected. Identification and quantity of O. vulgare’s volatile oil constituents were made on the basis of their retention times, the peak area of spectrograms and their mass spectra, which were confirmed by comparison with data from the Wiley mass spectral library.22
Formulation preparation
All formulation produced were o/w. Emulsions with varying droplet sizes named E (conventional emulsion) and N (nanoemulsion that included nano-sized droplets) were generated to evaluate their antimicrobial properties. The E emulsion was derived by emulsifying the essential oil (1% w/v) with the water phase consisting of Tween 80 and homogenization was achieved with an IKA Mixing Overhead Stirrer, Eurostar (IKA, Werke, Germany) at 1000 rpm for 10 minutes and then decreased to 500 rpm for 10 minutes. The N emulsions were generated by high-speed homogenizer using fixed essential oil concentration (1% w/v), nonionic surfactant (Tween 80, Tween 20, Span 80) and deionized water. Water was added to the organic phase contained surfactant and oil in various surfactant to oil ratio (SOR) with different hydrophilic-lipophilic balance (HLB) and simply mixed using a high-speed homogenizer (Silent Crusher M, Heidolph, Germany) at 8000 rpm for 15 minutes. Then the prepared emulsion was subjected to sonication using an ultrasonic sonicator (HD 3200, Bandelin, Germany) operating at a constant frequency of 20 kHz and amplitude (AM) of 25% equipped with a high-grade titanium tip for 10 min. With an outer ice-water bath, the temperature of the nanoemulsions was kept below 15°C across processing. All prepared nanoemulsions were stored at 25°C and the size and polydispersity index (PDI) of the different formulations were analyzed and finally, the most suitable formulation from a series of preliminary experiments was selected for this study.
Characterization of nanoemulsion
The droplet size and PDI of the nanoemulsion particles were analyzed by the photon correlation spectroscopy instrument (Zetasizer ZS, Malvern UK). Nanoemulsion was diluted with water (1:10) for measurement. Assessment were made in triplicate and the average droplet size was represented as the mean diameter.23
Transmission electron microscopy (TEM)
Morphology of the nanoemulsion droplets was determined by TEM using a Philips EM 208 S instrument. One drop of nanoemulsion was placed on a copper grid then stained by phosphotungstic acid solution 2% for 1 minute. The grid was observed at an acceleration voltage of 100 kV.
Time stability of nanoemulsions
The stability of nanoemulsions was assessed by analyzing the droplet size changes at room temperature during 30 days of storage.
Microbial culture and preparation of inoculum suspensions
To reviving freeze-dried microorganisms, the bacterial strains were cultured in Tryptic Soy agar plates for 24 hours at 35°C, C. albicans and A. niger in Sabouraud Dextrose agar plates at 25°C for 24-48 hours and 1 week respectively. Short term storage of each culture was stored at 4°C as working stocks. Before each experiment, fresh culture of each strain was prepared by streaking colonies from working stock on fresh plates to obtain cells in stationary growth phase (all strain cultured in the above-mentioned condition). After incubation, well-isolated colonies were removed with a sterile wire loop and suspended in sterile saline water to obtain a standardized suspension. The turbidity of the C. albicans and bacterial suspensions were adjusted to 0.5 McFarland standard (equivalent to (1-5) × 106 CFU/mL and (1-2) × 108 CFU/mL) respectively. A. niger spores were suspended in sterile normal saline containing 0.05% Tween 20 and the turbidity was measured at 530 nm and transmission was adjusted to 80%-82%, corresponding to (0.5-4.5) × 106 CFU/mL.24
Determination of minimum inhibitory concentration (MIC)
The MIC is the lowest antimicrobial agent concentration that inhibits the visible growth of the microorganism tested and measures a bacteriostatic effect of them without any data on the condition the microorganism population.25
The MIC of prepared formulation for the tested microorganisms was specified as the value where no microorganism growth was observed in comparison with the control tubes.
Macro dilution is one of the most basic antimicrobial reliable testing methods that involved a 2-fold serial dilution of the original antimicrobial agents tubes.26 Serial 2-fold dilutions (1/2, 1/4, 1/8, 1/16, 1/32, 1/64, 1/128, 1/256) of 1% (w/v) nanoemulsion and emulsion, ranging from 5 to 0.039 (mg/mL), were made in sterile tube contained 5 mL Tryptic Soy broth. Finally, standard inoculum suspensions were added to each tube as the final concentration of the bacteria and C. albicans were 5 × 105, (0.5-2.5) × 103 and for A. niger was (0.4-5) × 104 CFU/mL. After mixing, tubes are incubated at 35°C for 20-48 hours.26 Appropriate controls, including tubes with microorganism but no nanoemulsion/emulsion and tubes with nanoemulsion/emulsion dilutions but no microorganism, were simultaneously investigated. The examinations were performed in triplicate.
Determination of minimum bactericidal/fungicidal concentration (MBC/MFC)
MBC/MFC was determined after assessing the MIC of the prepared formulation by adding 100 μl from tubes that had no visible microorganism growth to a suitable medium. Tryptic soy agar and Sabouraud Dextrose agar were chosen for bacterial and fungi strains respectively. The petri dishes were then incubated for 24 hours at 35°C, (except A. niger 48 hours). The MBC/MFC value is characterized as the lowest concentration of antimicrobial agent that kills >99.9% of the primary colony where no visible growth of the microorganism was observed. All assays were repeated three times.27
Agar well diffusion assay
The antibacterial activity of emulsion and nanoemulsion of O. vulgare’s essential oil was carried out by agar well diffusion method.28 The standard inoculum suspensions of each bacteria and fungi were streaked on the Muller Hinton agar and Sabouraud Dextrose agar Petri dishes using sterile swap, respectively. Later agar media plates were punctured in 0.6 cm diameter by a sterile borer and each well separately loaded with 100 µL of different concentrations of nanoemulsion and emulsion ranging from 10 to 1.25 (mg/mL). The zone diameters of inhibition in the petri dishes were recorded after 16-18 hours of incubation for bacteria, 20-24 hours for C. albicans and 2-3 days for A. niger at 35°C.26 Amikacin, gentamycin, vancomycin, and amphotericin B were used as a positive control.
Statistical analysis
All data were reported as mean ± standard deviation (SD), resulting from the assays. The statistical significance of the variations was investigated by SPSS software Version 16 using one-way variance analysis (ANOVA) and statistical significance was accepted at a level of P <0.05.
Results and Discussion
Essential oil composition
The yield of essential oil from O. vulgare was 0.1 % (w/w), respectively. The main constituents identified in O. vulgare ’s essential oil are listed in Table 1. Eleven components involving 97.99% of total concentration of the essential oil. Carvacrol (78.46%), thymol (7.88%), benzene (7.03%) and gamma-terpinene (4.38%) were the main compounds identified in O. vulgare subsp . vulgare collected from the Hezarjirib region of Mazandaran in Iran.
Table 1.
Origanum vulgare’s essential oil composition
|
Components
|
Retention time (R
t
)
|
Relative area (%)
|
|
β-Pinene |
9.184 |
0.05 |
| p-Menthane |
9.664 |
0.02 |
| Benzene |
11.026 |
7.03 |
| 1,8-Cineol |
11.186 |
0.06 |
| o-Cymene |
11.450 |
0.02 |
| Gamma-terpinene |
12.199 |
4.38 |
| Trans-beta-ocimene |
11.839 |
0.03 |
| Sabinene |
12.623 |
0.02 |
| Beta-phellandrene |
12.668 |
0.04 |
| Thymol |
19.483 |
7.88 |
| Carvacrol |
20.279 |
78.46 |
Formulation preparation
Different formulations were tested to providing the most stable nanoemulsion form of O. vulgare’s essential oil (1%) as antimicrobial purpose. Formulation, HLB, mean droplet size, and PDI are reported in Table 2. The mixed surfactants HLB values are a critical factor in emulsion droplet formation. The lipophilic surfactants have a greater affinity than the hydrophilic surfactant to the dispersed droplets in the emulsion during the forming of an o/w emulsion.29 To maintain the balance of the water and oil phases, proper HLB values are needed. During emulsification, the newly formed droplets are stabilized and their droplet size is maintained at an optimum HLB value. With an HLB value of 7.87, the droplet size was 366 nm, and by rising the HLB value to 15 the size of the droplet was 72 nm. The ratio of surfactant to oil is a significant factor that affects droplet size. Increasing the emulsifier amount will result in increased adsorption around the oil-water droplet interface and decreased process interface tension to form nanoemulsion with smaller droplets.30 The interface tension which is directly relevant to the SOR should be set to a suitable amount for the optimal droplet size distribution. At different SOR, nanoemulsion was prepared separately, and PDI of formulation observed by dynamic light scattering technique are shown in Table 2. At SOR 1:1, the PDI was obvious as multi branches, one branch with a significant amount of droplets in the range of nanometers, and some other branch with a range of micrometers, indicating that due to the emulsifier deficiency, the oil cannot be fully emulsified. As the SOR increased, the particle size distribution decreased significantly (P <0.05). More specifically, the formulations differed in the choice of the emulsifiers and surfactants, which ranged from Tween 20, Tween 80 and Span 80. The results showed that the lowest particle size and the most suitable PDI were obtained with Tween 80 as surfactant and SOR 3:1. However, the use of ultrasonication significantly reduced the particle size (P <0.05). But without this equipment and only with the aid of highspeed homogenizer nanometer particles were obtained and finally, formulation F2 was selected.
Table 2.
Composition (% w/v ) of Origanum vulgare essential oil nanoemulsion
|
Formulations
|
Essential oil
|
Tween 80
|
Tween 20
|
Span 80
|
Deionized water (ml)
|
Sonication
|
SOR
|
HLB
|
Mean diameter (nm)
|
PDI [-]
|
| F1 |
1 |
1 |
- |
- |
Up to 100 |
|
1 |
15 |
42.56±4.15 |
0.473±0.032 |
| F2 |
1 |
3 |
- |
- |
Up to 100 |
|
3 |
15 |
72.26±3.62 |
0.113±0.005 |
| F3 |
1 |
4 |
- |
- |
Up to 100 |
|
4 |
15 |
78.96±3.65 |
0.106±0.005 |
| F4 |
1 |
3 |
- |
- |
Up to 100 |
10 min AM 25% |
3 |
15 |
48.76±2.34 |
0.19±0.01 |
| F5 |
1 |
3 |
- |
- |
Up to 100 |
10 min AM 50% |
3 |
15 |
52.5±2.75 |
0.196±0.015 |
| F6 |
1 |
- |
1 |
- |
Up to 100 |
|
1 |
16.7 |
81.63±3.32 |
0.443±0.051 |
| F7 |
1 |
- |
2 |
- |
Up to 100 |
|
2 |
16.7 |
77.06±3.70 |
0.326±0.033 |
| F8 |
1 |
- |
4 |
- |
Up to 100 |
|
4 |
16.7 |
207.43±6.41 |
0.156±0.015 |
| F9 |
1 |
1 |
- |
2 |
Up to 100 |
|
3 |
7.87 |
366.23±13.25 |
0.936±0.056 |
| F10 |
1 |
1.5 |
- |
1.5 |
Up to 100 |
|
3 |
9.65 |
343.06±12.15 |
0.9±0.04 |
Transmission electron microscopy
TEM characterization of essential oil nanoemulsion showed the spherical and homogeneous shape of droplets (Figure 1). TEM micrograph also confirmed the results obtained from droplet size analysis using the dynamic light scattering with diameter <80 nm.

Figure 1.
Transmission electron micrograph of essential oil nanoemulsion (F2).
.
Transmission electron micrograph of essential oil nanoemulsion (F2).
Time stability of nanoemulsions
Changes in droplet size are shown in Figure 2 as a function of the storage time of nanoemulsions stored at room temperature. The droplet size raised very rapidly at room temperature during the initial 7 days of observation. The growth rate slowed down after 7 days, but the size of the nanoemulsions was still within appropriate range. The droplet size increased from 72 nm on production day to 109 nm on storage day 30.

Figure 2.
Stability of nanoemulsion (F2) stored at room temperature.
.
Stability of nanoemulsion (F2) stored at room temperature.
MIC, MBC and MFC of nanoemulsion and emulsion
In the present study, the MIC and MBC/MFC of emulsion and nanoemulsion of O. vulgare’s essential oil were evaluated against several microorganisms known as foodborne pathogens. Generally, the MIC and MBC/MFC values of emulsion and nanoemulsion for the tested bacteria and fungi were found to be similar. The MIC of these agents against the tested bacteria were in the range of 0.156 to 0.312 (mg/mL) and against the tested fungi were in the range of 0.078 to 0.156 (mg/mL). The MBC/MFC of both emulsion and nanoemulsion against the tested microorganisms were in the range of 0.312 to 5 (mg/mL) and both of them had no effect on B. subtilis, P. aeruginosa, and A. niger. All of these findings are summarized in Table 3.
Table 3.
MIC, MBC and MFC values (mg/mL) of nanoemulsion (N) and emulsion (E) forms of O. vulgare’sessential oil on selected microorganisms determined by macro dilution method
|
|
S. aureus
|
E. coli
|
B. subtilis
|
P. aeruginosa
|
S. typhi
|
C. albicans
|
A.
niger
|
|
N
|
E
|
N
|
E
|
N
|
E
|
N
|
E
|
N
|
E
|
N
|
E
|
N
|
E
|
| MIC |
0.312 |
0.312 |
0.312 |
0.312 |
0.312 |
0.312 |
- |
- |
0.156 |
0.156 |
0.156 |
0.156 |
0.078 |
0.078 |
| MBC, MCF |
5 |
5 |
5 |
5 |
- |
- |
- |
- |
2.5 |
2.5 |
0.312 |
0.312 |
- |
- |
Agar well diffusion assay
The antimicrobial activity of the nanoemulsion of O. vulgare’s essential oil in different concentration (1.25-10 mg/mL) was evaluated by measuring the diameter of the inhibition zone using an agar well diffusion method shown in Table 4. It is clear that the emulsion and nanoemulsion form demonstrated significant activity against the S. aureus, C. albicans and A. niger (Figures 3-5) with inhibition zones ranging from 8.7–22.3mm, however, this agent had no inhibition effect on E. coli, P. aeruginosa, B. subtilis, and S. typhi. Control treatments (amikacin, gentamycin, amphotericin B and vancomycin) showed an inhibitory effect on tested microorganisms by inhibition zones ranging from 15.3–30.3 mm.

Figure 3.
Zone of inhibition on A. niger by agar well diffusion. A) Nanoemulsion B) Emulsion.
.
Zone of inhibition on A. niger by agar well diffusion. A) Nanoemulsion B) Emulsion.
Figure 4.
Zone of inhibition on C. albicans by agar well diffusion. A) Nanoemulsion B) Emulsion.
.
Zone of inhibition on C. albicans by agar well diffusion. A) Nanoemulsion B) Emulsion.
Figure 5.
Zone of inhibition on S. aureus by agar well diffusion A) Nanoemulsion B) Emulsion C) Antibiotics as control.
.
Zone of inhibition on S. aureus by agar well diffusion A) Nanoemulsion B) Emulsion C) Antibiotics as control.
Table 4.
Means of the inhibition diameters (mm) of nanoemulsion (N) and emulsion (E) forms of O. vulgare’sessential oil on selected microorganisms determined by agar well diffusion compared to standard drugs
|
Concentration
|
S. aureus
|
E. coli
|
B. subtilis
|
P. aeruginosa
|
S. typhi
|
C. albicans
|
A.
niger
|
|
N
|
E
|
N
|
E
|
N
|
E
|
N
|
E
|
N
|
E
|
N
|
E
|
N
|
E
|
| 1.25 mg/mL |
- |
- |
- |
- |
- |
- |
- |
- |
- |
- |
8.7±0.1 |
- |
- |
- |
| 2.5 mg/mL |
13±0.3 |
11.2±0.2 |
- |
- |
- |
- |
- |
- |
- |
- |
9.5±0.2 |
9.3±0.2 |
- |
- |
| 5 mg/mL |
18.6±0.7 |
14.6±0.8 |
- |
- |
- |
- |
- |
- |
- |
- |
14.2±0.2 |
10.8±0.3 |
11.2±0.4 |
10.3±0.3 |
| 10 mg/mL |
22.3±0.8 |
16.8±0.6 |
- |
- |
- |
- |
- |
- |
- |
- |
20.6±0.9 |
16.5±0.8 |
18±0.5 |
13.4±0.4 |
| Amikacin (30 µg/mL) |
23.1±0.7 |
23±0.6 |
30.3±0.5 |
19.4±0.6 |
24.2±0.6 |
- |
- |
| Gentamycin (10 µg/mL) |
23.4±0.5 |
24.2±0.7 |
29.3±0.7 |
16.5±0.8 |
27.2±0.7 |
- |
- |
| Vancomycin (10 µg/mL) |
20.1±0.4 |
- |
26.9±0.7 |
- |
- |
- |
- |
| Amphotericin B (100 µg/mL) |
- |
- |
- |
- |
- |
15.9±0.3 |
15.3±02 |
Plant essential oils have been observed as useful sources of antimicrobial agents and can be an appropriate antibacterial preservative at a concentration which does not turn out unfavorable changes in the flavor of food products but a few preservatives containing essential oils are already commercially available. O. vulgare is commonly recognized as having medicinal properties and its essential oil used in the food, agricultural, pharmaceutical and cosmetic industries and has shown antimicrobial activity against microorganisms.1 Essential oils, however, have low water solubility and this is a limiting factor for their usage as antimicrobial agents. A nanoemulsion of O. vulgare essential oil can solve the problem of low water solubility, so the purpose of this study was to promote and evaluate nanoemulsion formulations of oregano essential oil for its antimicrobial activity in comparison with emulsion form and standard amikacin, gentamycin, vancomycin, amphotericin B antibiotics (positive control).
There is currently a new trend in the use of natural plant substances as well as essential oils as natural antimicrobial agents to combat microbial spoilage with nanoformulations. Therefore, novel approaches are urgently needed to develop new green antimicrobial agents based on nanoformulations of essential oils as an alternative to synthetic anti-microbial preservatives for spoilage prevention. A silver nanoparticle from O. vulgare’s aqueous leaf extract has been green synthesized by reducing the solution of silver nitrate and this silver nanoparticles showed effective antimicrobial activity against some human pathogenic bacterial strains (namely: A. hydrophila, Bacillus spp., E. coli, Salmonella spp., S. paratyphi, Klebsiella spp., S. dysenteriae, S. sonnei) by agar well diffusion method compared to standard reference drug (chloramphenicol). The enhancing effect of bioactive compounds such as thymol and carvacrol was reported.15 Phenolic compounds like thymol, eugenol, and carvacrol compare to other constituents in the essential oils possess the noticeable antimicrobial activity31,32 and this effect is probably due to the interaction of the hydroxyl group of their molecules with the cell membrane and likely acts as donor of proton, that is a carrier of protons across the lipid bilayers, therefore causing the waste of the proton movement energy and finally causing leakage of cellular substances like potassium ions, increase in concentration of the saturated fatty acids and change phospholipids profiles membrane and causing membrane structural alterations, decrease of intracellular ATP as well as the increase of extracellular ATP.19,33 Baydar et al. reported the possibility of using the essential oils of the wild oregano (Origanum minutiflorum), oregano (Origanum onites) as natural food preservatives to preventing the growth of foodborne pathogens at 2% concentration and extending the shelf life of processed foods, due to the presence of the high amount phenolic compounds like carvacrol (about 80%) and to the hydrocarbons c-terpinene and p-cymene that possess strong antimicrobial properties.34 Analysis of essential oil composition of O. vulgare subsp. glandulosum (Desf.) and antibacterial activity against S. aureus, B. subtilis, E. coli, S. typhimurium, P. aeruginosa were investigated and the results closed to our study, high level of carvacrol about 80% and the inhibition zones and MIC values reported in the range of 9–36 mm and 125–600 μg/mL, respectively.35 Also, antimicrobial activity of O. vulgare’s essential oil was evaluated up to 72 h against foodborne pathogens (S. aureus, L. monocytogenes, S. enteritidis, C. jejuni) through disk diffusion and determination of MIC, that showed the 0.5% concentration of the essential oil of O. vulgare could be used as food additives without considerably making different the flavor of food and be able to act as bacteriostatic and bactericidal against high and low pathogen concentrations.31 In a previous study, Origanum compactum’s essential oil (2%) containing phenolic compounds like thymol and eugenol has been showed antimicrobial effect on E. coli and B. subtilis by inducing cell lysis and stimulating damage in the bacterial envelope, which plays a fundamental role in the life of bacteria. The results for E. coli were similar to those for polymyxin B and scanning electronic microscope observations revealed that both cell wall and membrane of the treated bacteria were significantly damaged36 however, in our study O. vulgare essential oil emulsion and nanoemulsion form in concentration up to 1 % showed no inhibition growth of E. coli and B. subtilis. Similarly, a nanoemulsion of thyme oil (Thymus vulgaris L.) prepared containing Tween 80 (3% v/v), Alginate dispersions and glycerol in a high-speed blender at room temperature for enhancing encapsulation of essential oil to obtaining functional edible film that exhibited strong inhibitory effect against inoculated E. coli because of high content of thymol in it. Thymol molecules can attach to the membrane proteins of microorganisms by hydrophobic interactions, thereby altering the permeability of the membrane, which may help to protect and preserve food products.18 As mentioned in the results, the nanoemulsion form of O. vulgare’s essential oil showed a specific effect on the fungi that confirms the presence of high content of phenolic compounds in it (Figures 3 and 4).
Conclusion
In conclusion, design and suggestion of an appropriate emulsifier in the final formulation of the nanoemulsion form of O. vulgare essential oil (1%) exhibited significant activity against the S. aureus, C. albicans, and A. niger and it could be new antimicrobial agents with great potential usage in food industries as food preservatives. In fact, it is probably a delivery system capable of ensuring a lower concentration of antimicrobial compounds such as essential oils in the aqueous phase.
Ethical Issues
Not applicable.
Conflict of Interest
The authors declare no conflict of interest.
Acknowledgments
This research was supported by grants from the Mazandaran University of Medical Sciences, Sari, Iran (no. 2219).
References
- Burt S. Essential oils: their antibacterial properties and potential applications in foods--a review. Int J Food Microbiol 2004; 94(3):223-53. doi: 10.1016/j.ijfoodmicro.2004.03.022 [Crossref] [ Google Scholar]
- Moghimi R, Ghaderi L, Rafati H, Aliahmadi A, McClements DJ. Superior antibacterial activity of nanoemulsion of Thymus daenensis essential oil against E coli. Food Chem 2016; 194:410-5. doi: 10.1016/j.foodchem.2015.07.139 [Crossref] [ Google Scholar]
-
Faleiro ML. The mode of antibacterial action of essential oils. In: Méndez-Vilas A, ed. Science Against Microbial Pathogens: Communicating Current Research and Technological Advances. Formatex Research Center; 2011. p. 1143-56.
- Alzoreky NS, Nakahara K. Antibacterial activity of extracts from some edible plants commonly consumed in Asia. Int J Food Microbiol 2003; 80(3):223-30. doi: 10.1016/s0168-1605(02)00169-1 [Crossref] [ Google Scholar]
-
Callaway TR, Carroll JA, Arthington JD, Edrington TS, Anderson RC, Ricke SC, et al. Citrus products and their use against bacteria: potential health and cost benefits. In: Gerald J, Watson R, Preedy V, eds. Nutrients, Dietary Supplements, and Nutriceuticals. Humana Press; 2011. p. 277-86. 10.1007/978-1-60761-308-4_17
- Torbati M, Nazemiyeh H, Lotfipour F, Nemati M, Asnaashari S, Fathiazad F. Chemical composition and in vitro antioxidant and antibacterial activity of Heracleum transcaucasicum and Heracleum anisactis roots essential oil. Bioimpacts 2014; 4(2):69-74. doi: 10.5681/bi.2014.004 [Crossref] [ Google Scholar]
- Akbari J, Saeedi M, Farzin D, Morteza-Semnani K, Esmaili Z. Transdermal absorption enhancing effect of the essential oil of Rosmarinus officinalis on percutaneous absorption of Na diclofenac from topical gel. Pharm Biol 2015; 53(10):1442-7. doi: 10.3109/13880209.2014.984855 [Crossref] [ Google Scholar]
- Fisher K, Phillips C. Potential antimicrobial uses of essential oils in food: is citrus the answer?. Trends Food Sci Technol 2008; 19(3):156-64. doi: 10.1016/j.tifs.2007.11.006 [Crossref] [ Google Scholar]
- Gyawali R, Ibrahim SA. Natural products as antimicrobial agents. Food Control 2014; 46:412-29. doi: 10.1016/j.foodcont.2014.05.047 [Crossref] [ Google Scholar]
- Prakash B, Kedia A, Mishra PK, Dubey NK. Plant essential oils as food preservatives to control moulds, mycotoxin contamination and oxidative deterioration of agri-food commodities–potentials and challenges. Food Control 2015; 47:381-91. doi: 10.1016/j.foodcont.2014.07.023 [Crossref] [ Google Scholar]
- Calo JR, Crandall PG, O’Bryan CA, Ricke SC. Essential oils as antimicrobials in food systems-a review. Food Control 2015; 54:111-9. doi: 10.1016/j.foodcont.2014.12.040 [Crossref] [ Google Scholar]
- Ferreira JP, Alves D, Neves O, Silva J, Gibbs PA, Teixeira PC. Effects of the components of two antimicrobial emulsions on food-borne pathogens. Food Control 2010; 21(3):227-30. doi: 10.1016/j.foodcont.2009.05.018 [Crossref] [ Google Scholar]
- Giatrakou V, Ntzimani A, Savvaidis IN. Effect of chitosan and thyme oil on a ready to cook chicken product. Food Microbiol 2010; 27(1):132-6. doi: 10.1016/j.fm.2009.09.005 [Crossref] [ Google Scholar]
- Habibi E, Shokrzadeh M, Ahmadi A, Chabra A, Naghshvar F, Keshavarz-Maleki R. Genoprotective effects of Origanum vulgare ethanolic extract against cyclophosphamide-induced genotoxicity in mouse bone marrow cells. Pharm Biol 2015; 53(1):92-7. doi: 10.3109/13880209.2014.910674 [Crossref] [ Google Scholar]
- Sankar R, Karthik A, Prabu A, Karthik S, Shivashangari KS, Ravikumar V. Origanum vulgare mediated biosynthesis of silver nanoparticles for its antibacterial and anticancer activity. Colloids Surf B Biointerfaces 2013; 108:80-4. doi: 10.1016/j.colsurfb.2013.02.033 [Crossref] [ Google Scholar]
- Souza EL, Stamford TLM, Lima EO, Trajano VN. Effectiveness of Origanum vulgare L essential oil to inhibit the growth of food spoiling yeasts. Food Control 2007; 18(5):409-13. doi: 10.1016/j.foodcont.2005.11.008 [Crossref] [ Google Scholar]
- Marino M, Bersani C, Comi G. Impedance measurements to study the antimicrobial activity of essential oils from Lamiaceae and Compositae. Int J Food Microbiol 2001; 67(3):187-95. doi: 10.1016/s0168-1605(01)00447-0 [Crossref] [ Google Scholar]
- Acevedo-Fani A, Salvia-Trujillo L, Rojas-Graü MA, Martín-Belloso O. Edible films from essential-oil-loaded nanoemulsions: Physicochemical characterization and antimicrobial properties. Food Hydrocoll 2015; 47:168-77. doi: 10.1016/j.foodhyd.2015.01.032 [Crossref] [ Google Scholar]
- Donsì F, Annunziata M, Vincensi M, Ferrari G. Design of nanoemulsion-based delivery systems of natural antimicrobials: effect of the emulsifier. J Biotechnol 2012; 159(4):342-50. doi: 10.1016/j.jbiotec.2011.07.001 [Crossref] [ Google Scholar]
- Liolios CC, Gortzi O, Lalas S, Tsaknis J, Chinou I. Liposomal incorporation of carvacrol and thymol isolated from the essential oil of Origanum dictamnus L and in vitro antimicrobial activity. Food Chem 2009; 112(1):77-83. doi: 10.1016/j.foodchem.2008.05.060 [Crossref] [ Google Scholar]
- Gortzi O, Lalas S, Chinou I, Tsaknis J. Reevaluation of bioactivity and antioxidant activity of Myrtus communis extract before and after encapsulation in liposomes. Eur Food Res Technol 2008; 226(3):583-90. doi: 10.1007/s00217-007-0592-1 [Crossref] [ Google Scholar]
-
Adams RP. Identification of Essential Oil Components by Gas Chromatography/Mass Spectrometry. 4th ed. USA: Allured Publishing Corporation; 2007.
- Fernandes CP, Mascarenhas MP, Zibetti FM, Lima BG, Oliveira RP, Rocha L. HLB value, an important parameter for the development of essential oil phytopharmaceuticals. Rev Bras Farmacogn 2013; 23(1):108-14. doi: 10.1590/s0102-695x2012005000127 [Crossref] [ Google Scholar]
- Rodríguez-Tudela JL, Cuenca-Estrella M, Díaz-Guerra TM, Mellado E. Standardization of antifungal susceptibility variables for a semiautomated methodology. J Clin Microbiol 2001; 39(7):2513-7. doi: 10.1128/jcm.39.7.2513-2517.2001 [Crossref] [ Google Scholar]
- Sarikurkcu C, Zengin G, Oskay M, Uysal S, Ceylan R, Aktumsek A. Composition, antioxidant, antimicrobial and enzyme inhibition activities of two Origanum vulgare subspecies (subsp vulgare and subsp hirtum) essential oils. Ind Crops Prod 2015; 70:178-84. doi: 10.1016/j.indcrop.2015.03.030 [Crossref] [ Google Scholar]
- Balouiri M, Sadiki M, Ibnsouda SK. Methods for in vitro evaluating antimicrobial activity: a review. J Pharm Anal 2016; 6(2):71-9. doi: 10.1016/j.jpha.2015.11.005 [Crossref] [ Google Scholar]
- Heling I, Rotstein I, Dinur T, Szwec-Levine Y, Steinberg D. Bactericidal and cytotoxic effects of sodium hypochlorite and sodium dichloroisocyanurate solutions in vitro. J Endod 2001; 27(4):278-80. doi: 10.1097/00004770-200104000-00009 [Crossref] [ Google Scholar]
- Natarajan D, Britto SJ, Srinivasan K, Nagamurugan N, Mohanasundari C, Perumal G. Anti-bacterial activity of Euphorbia fusiformis-a rare medicinal herb. J Ethnopharmacol 2005; 102(1):123-6. doi: 10.1016/j.jep.2005.04.023 [Crossref] [ Google Scholar]
- Lu WC, Huang DW, Wang CR, Yeh CH, Tsai JC, Huang YT. Preparation, characterization, and antimicrobial activity of nanoemulsions incorporating citral essential oil. J Food Drug Anal 2018; 26(1):82-9. doi: 10.1016/j.jfda.2016.12.018 [Crossref] [ Google Scholar]
- Zhang Y, Shang Z, Gao C, Du M, Xu S, Song H. Nanoemulsion for solubilization, stabilization, and in vitro release of pterostilbene for oral delivery. AAPS PharmSciTech 2014; 15(4):1000-8. doi: 10.1208/s12249-014-0129-4 [Crossref] [ Google Scholar]
- Pesavento G, Calonico C, Bilia AR, Barnabei M, Calesini F, Addona R. Antibacterial activity of Oregano, Rosmarinus and Thymus essential oils against Staphylococcus aureus and Listeria monocytogenes in beef meatballs. Food Control 2015; 54:188-99. doi: 10.1016/j.foodcont.2015.01.045 [Crossref] [ Google Scholar]
- Lin PC, Lee JJ, Chang IJ. Essential oils from Taiwan: chemical composition and antibacterial activity against Escherichia coli. J Food Drug Anal 2016; 24(3):464-70. doi: 10.1016/j.jfda.2015.12.006 [Crossref] [ Google Scholar]
- Di Pasqua R, Betts G, Hoskins N, Edwards M, Ercolini D, Mauriello G. Membrane toxicity of antimicrobial compounds from essential oils. J Agric Food Chem 2007; 55(12):4863-70. doi: 10.1021/jf0636465 [Crossref] [ Google Scholar]
- Baydar H, Sağdiç O, Özkan G, Karadoğan T. Antibacterial activity and composition of essential oils from Origanum, Thymbra and Satureja species with commercial importance in Turkey. Food Control 2004; 15(3):169-72. doi: 10.1016/s0956-7135(03)00028-8 [Crossref] [ Google Scholar]
- Béjaoui A, Chaabane H, Jemli M, Boulila A, Boussaid M. Essential oil composition and antibacterial activity of Origanum vulgare subsp glandulosum Desf at different phenological stages. J Med Food 2013; 16(12):1115-20. doi: 10.1089/jmf.2013.0079 [Crossref] [ Google Scholar]
- Rhayour K, Bouchikhi T, Tantaoui-Elaraki A, Sendide K, Remmal A. The mechanism of bactericidal action of oregano and clove essential oils and of their phenolic major components on Escherichia coli and Bacillus subtilis. J Essent Oil Res 2003; 15(5):356-62. doi: 10.1080/10412905.2003.9698611 [Crossref] [ Google Scholar]